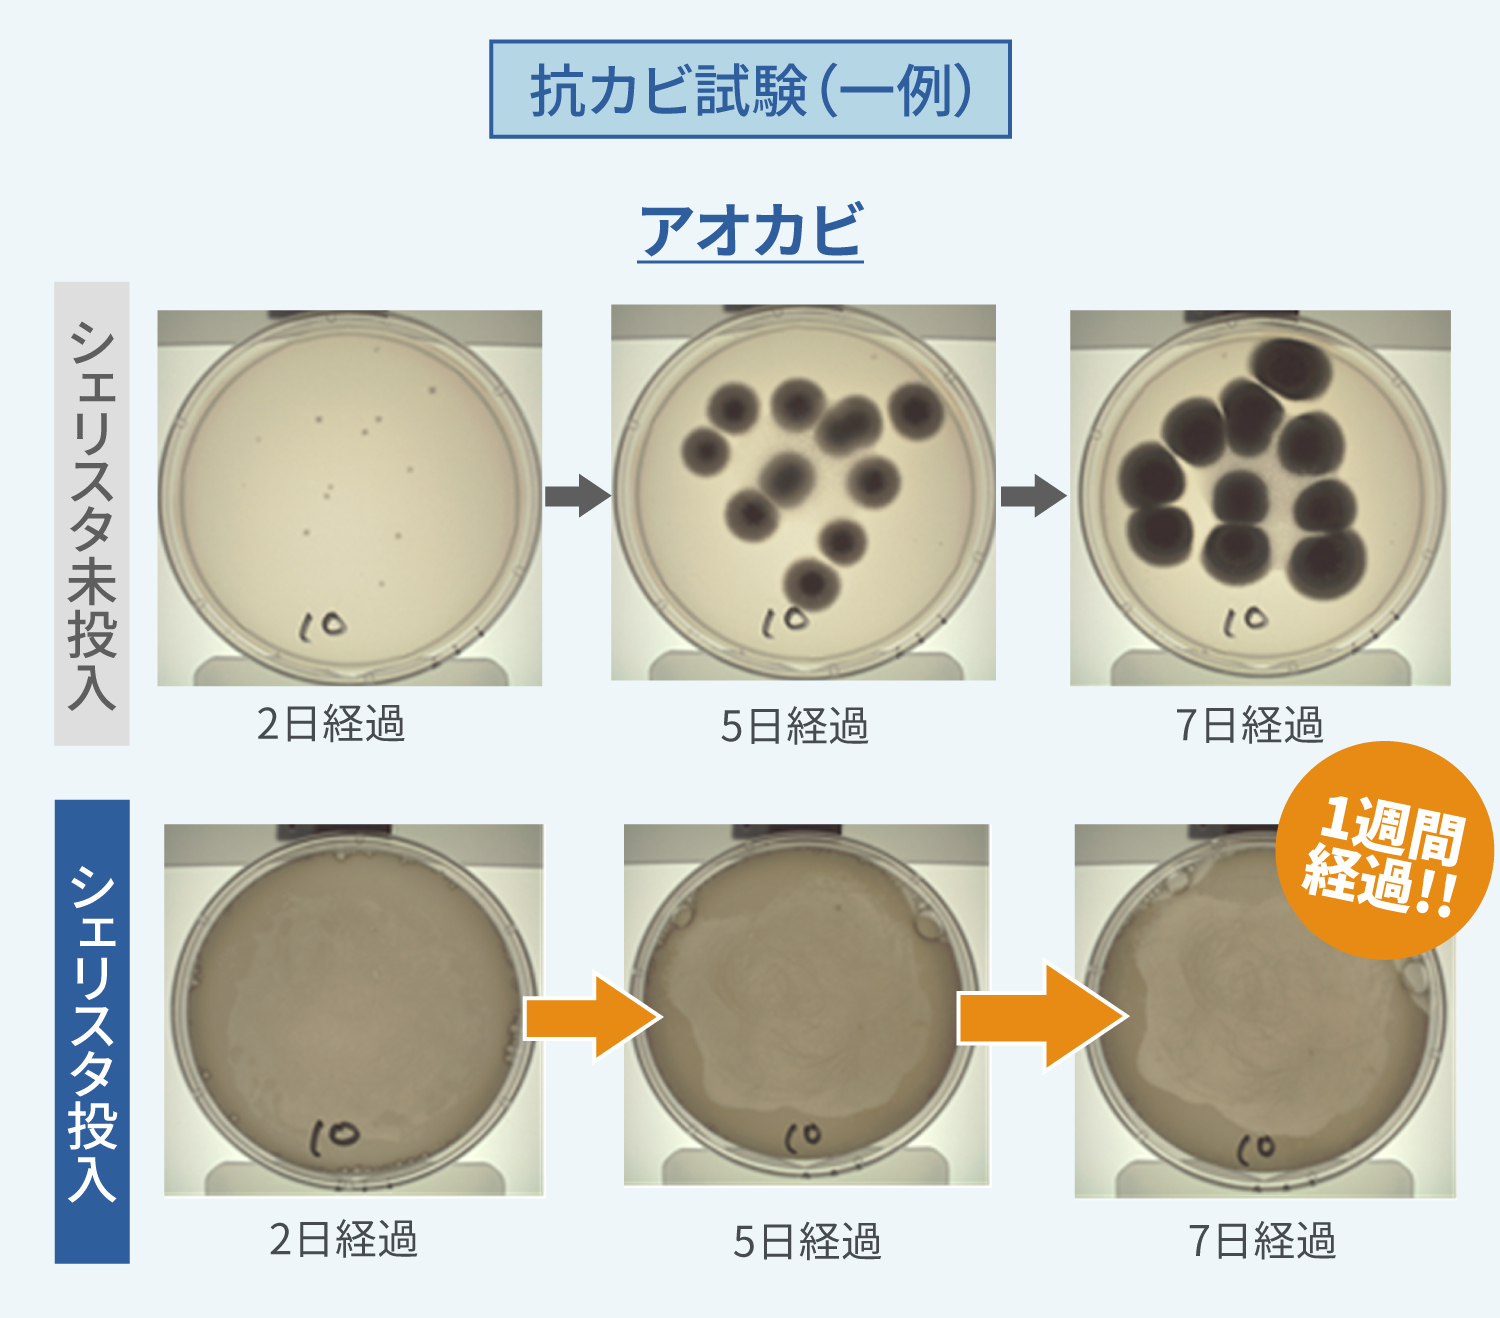
抗カビ試験結果1
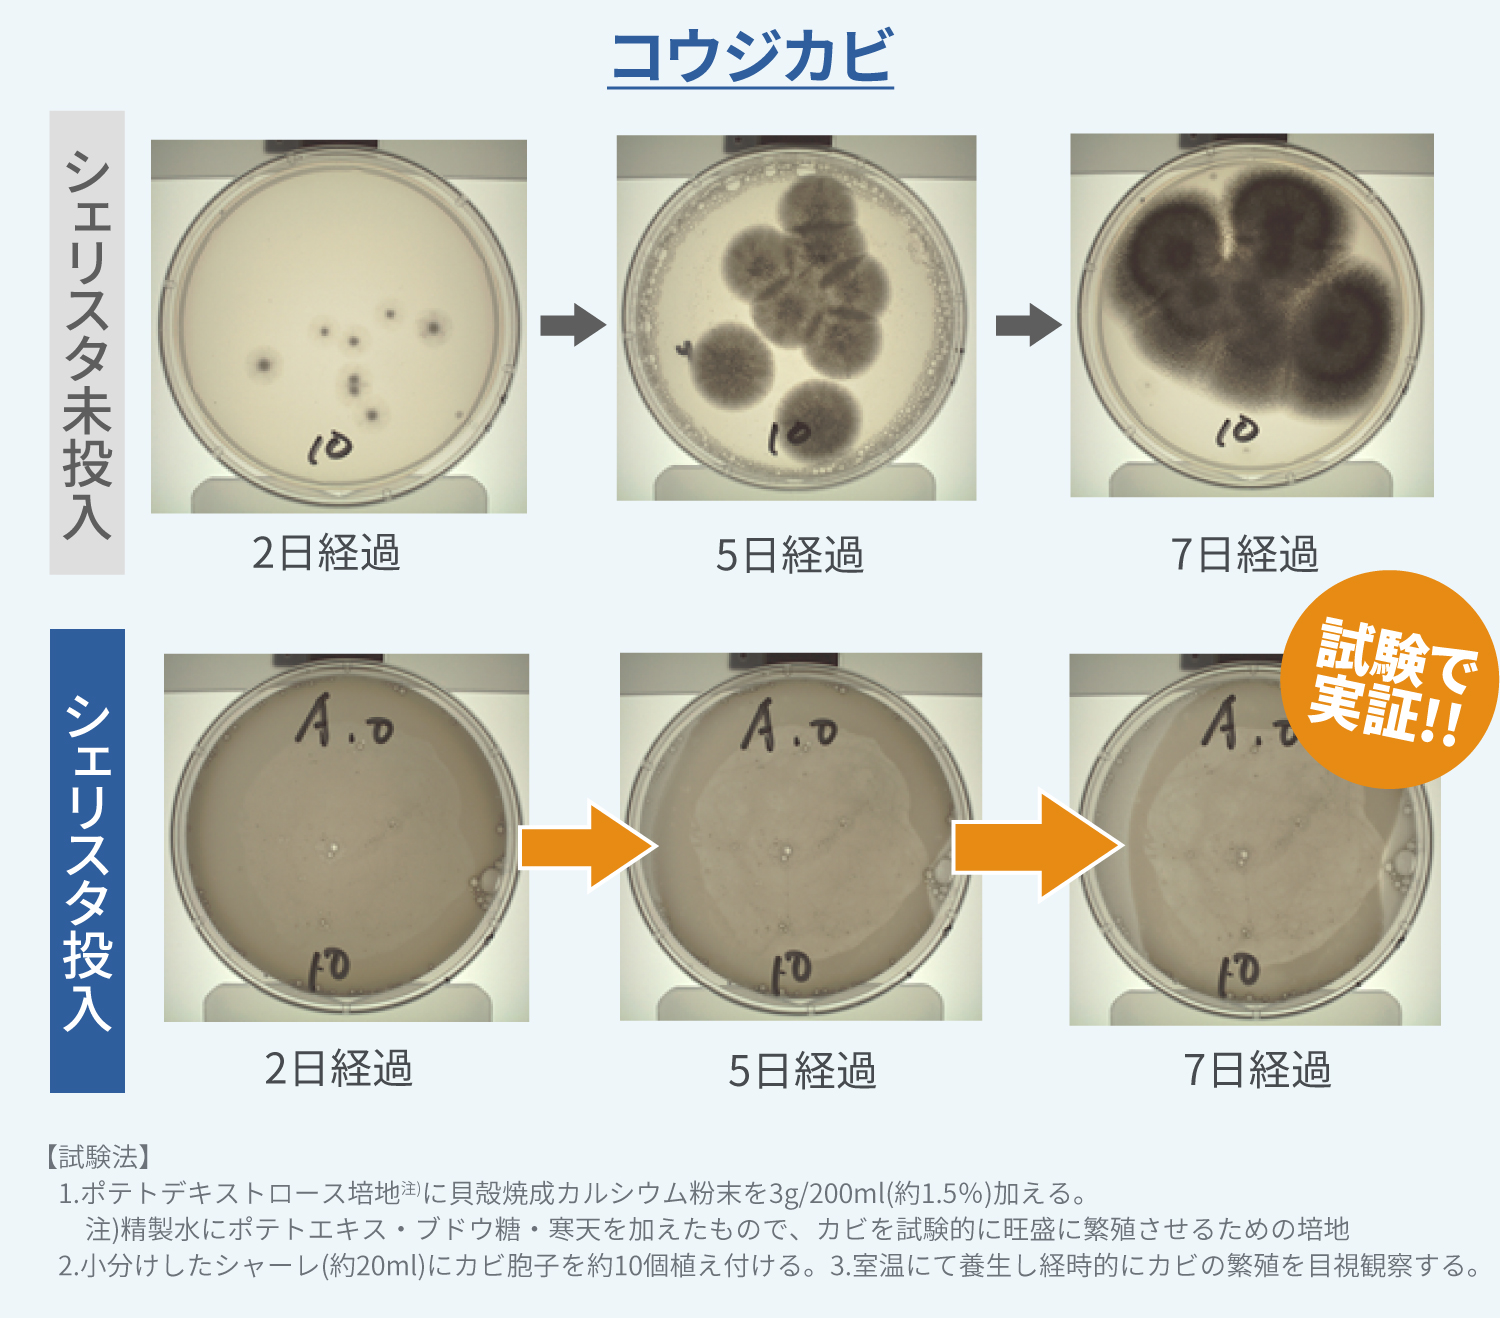
抗カビ試験結果2

シェリスタ除菌消臭スプレー

一般的な除菌洗浄剤や消臭スプレーとの違い
シェリスタ除菌消臭スプレーは、北海道オホーツク海産のホタテ貝殻を独自製法で加工して純水で溶かしたもので、強アルカリ性の力による除菌や消臭効果があります。天然成分と水だけなので、キッチン周りや冷蔵庫や衣類や自動車内など幅広い用途での除菌や消臭に安心して使うことができます。
まぜるな危険ではない

ドラッグストアやスーパーなどで売られている一般的な除菌洗浄剤の主成分は「次亜塩素酸ナトリウム」で、家庭用として塩素系漂白剤に、またプールの漂白剤として利用されています。このような製品は鼻をつく独特な臭いがあったり、他の洗剤と混ぜて塩素ガスを発生させてしまい死亡事故などが起こる危険性があります。これはいわゆる「まぜるな危険」と呼ばれるものです。シェリスタは化学成分が入っていない100%ナチュラルな成分なので、このような重篤な危険を考えずに使用することができます。
アルコールフリー

アルコール系の除菌消臭剤を使う場合、皮膚に付着して肌荒れや湿疹を起こしたり、臭いを嗅いだだけで気分が悪くなったり、呼吸困難になってしまう場合もあります。アルコール過敏症や喘息の方は、アルコール除菌消臭剤の取り扱いは慎重に行う必要があります。シェリスタにはアルコール成分が一切入っておりませんので、アルコールに敏感な方でも安心してご利用いただけます。
臭いを元から取り除く

日本で広く普及している消臭スプレーは、臭い成分を香りでコーティングして臭わなくするマスキング方式です。そのような臭いを香りで閉じ込めてごまかす消臭スプレーと違い、シェリスタは無香料ですが強アルカリ性の力で臭いの原因を元から取り除くことができます。無香料で消臭できるところにぜひ着目してください。
人にもペットにも環境にも安心

シェリスタは天然成分100%なので合成界面活性剤・保存料・着色料・香料は一切使用していません。そして食品添加物として使えるくらいですので、散布する場所や健康への影響を心配せずに、臭いや細菌・ウイルスが気になるところへ使えるのが特長です。また、主成分のホタテ貝殻は丁寧に洗浄消毒してリユースすることで環境にも配慮しています。赤ちゃんや小さいお子さまがいるご家庭や、健康に気を使われている方、エコや環境負荷に関心がある方など、シェリスタは人にも環境にも優しい除菌消臭スプレーです。
細菌やウイルスに高い除菌効果
様々な菌やウィルスが99.9%減少
さまざまな細菌が私たちの日常生活には潜んでいます。特に赤ちゃんや高齢者は細菌感染から身体への重篤な被害が考えられるので、適切な処置が求められています。シェリスタの除菌試験では、シェリスタに浸けた細菌が10分後には99.9%以上も除菌された結果も出ています。ナチュラル成分でもしっかりとした除菌効果を得られます。

ウィルスの除菌にも効果的
ウィルスとして代表的なのが非エンベロープタイプです。非エンベロープタイプは冬を中心に流行するのが特徴で、感染力が非常に高く、学校や病院など集団生活を行っている場所ではあっという間に集団感染に発展してしまうことが多々あります。家庭内での感染拡大を防ぐには、以下の3つが重要とされています。
- ①吐しゃ物や糞便を速やかに処理すること
- ②処理後の周辺を適切に除菌すること
- ③作業後には念入りに手洗いをすること
②の除菌方法で推奨されているのは、85℃で1分以上の加熱をするか、もしくは除菌剤を使用することです。非エンベロープタイプの除菌には逆性石けんやアルコール消毒では充分ではありません。シェリスタの除菌試験では非エンベロープタイプは10分後に78.5%減少しました。
悪臭にも強い消臭効果
日常生活で臭いが気になる場所はたくさんあります。例えば、三角コーナーやゴミ箱といったキッチン周りや、トイレや下駄箱や冷蔵庫、ペット用品、また自動車の中の臭いも気になるところです。このような臭いに、シェリスタは効果を発揮してくれます。消臭試験では「腐った卵の臭い」や「アンモニア」「蒸れた靴下」といった強烈な刺激臭もシェリスタ使用10分後には99.9%減少しました。

高い抗カビ効果
アオカビ・コウジカビ・クロコウジカビといった代表的なカビ菌に対するシェリスタの抗カビ効果を測った試験では、シェリスタを使わなかった時に比べて、7日間後でもカビの繁殖を抑制できる結果を得られました。お風呂場やキッチン、梅雨時や夏季の高温多湿の室内環境になるときに、シェリスタはたいへん効果的です。

いろいろな場所で使える
野菜や果物の洗浄や除菌、キッチンやトイレの除菌、赤ちゃん用品やペット用品の消臭・除菌など、お風呂や洗濯機、また自動車やソファやベッドといった、日常生活での幅広い用途にご使用いただけます。ぬいぐるみやオモチャ、ソファや自動車のシートなど簡単に洗濯できないものにシェリスタは効果的です。
子供のオモチャやぬいぐるみ

乳児はおもちゃなどを口に入れることが多いので日常的に除菌することがおすすめです。
ソファやベッド

化学的な成分やアルコールを一切使用していないので、身体への影響を気にする方にも安心です。
衣類や靴・くつ下

ニオイが気になるけれどなかなか洗えない衣類や靴にも。
車内のシートやフロアマット

食べ物のカスや汚れが溜まりやすい自動車のフロアマットや、汗が染み込んだシートなど、車内の臭いにも。
よくあるご質問
-
Q 消臭や除菌の効果はどのくらいから出始めますか?
-
A 10分程度で除菌消臭効果があらわれます。これは一般的な有機塩素系の消臭剤やアルコール系の消毒剤に比べると速効性は劣るかもしれませんが、除菌消臭効果に持続性があること、天然成分100%ということにメリットを感じていただけると思います。徐々に長く効果が続くイメージをしてもらえると分かりやすいかもしれません。
-
Q どのような菌が除菌できますか?
-
A すべての農薬や細菌・ウイルスに対して除菌検査等は行ってはおりませんが、様々な細菌やウィルスがほとんど検出されなくなった結果が出ています。
-
Q どんな場所に吹きかけても大丈夫ですか?
-
A 天然成分ですので基本的にはどこにでもお使いいただけます。臭いや菌の発生が気になる場所に吹きかけてお使いください。ただ【アルミニウム製品や銅製品】へ使用すると、変色・腐食する場合がございますのでご使用はお控えください。
-
Q 衣類などの布製品にスプレーできますか?
-
A はい、大丈夫です。天然成分で作られていますのでご使用いただけます。ただ【革製品】へ使用すると、染みや縮みの恐れがありますのでご使用はお控えください。
-
Q 鼻にツンとくる臭いが苦手なのですが、これは無臭ですか?
-
A はい、シェリスタは無臭です。一般的な除菌スプレーにありがちな化学的な臭いが苦手な方にもお勧めしています。

使用方法
臭いや細菌が気になるところへ本製品を20~30cm離して全体がしっとりする程度に吹きかけてください。
使用用途
[除菌・洗浄]
包丁やまな板の洗浄・除菌/排水口の除菌・ぬめり取り/ふきんの除菌/ソファやベッドの除菌/ぬいぐるみや玩具などベビー用品の除菌/自動車のシートやフロアマットの除菌
[消臭]
キッチンやトイレの消臭/生ゴミの消臭/下駄箱の消臭/おむつの消臭/冷蔵庫内の消臭/ペット用品の消臭/たばこの消臭/靴や衣服・くつ下の消臭
使用上の注意
- 用途以外に使用しないでください。
- 他の除菌剤や洗浄剤と混ぜないでください。
- 誤って目や粘膜に付着した場合は水で十分洗い流して、医師の診断を受けてください。
- 誤飲した場合はすぐにうがいをし、2~3杯の水を飲む等の処置をして医師に相談してください。
- 直射日光の当たらない涼しい場所、幼児の手の届かない場所に保管してください。
- 本製品はアルカリ性のため、アルミニウム製品・銅製品へのご使用はお控えください。
- 皮革製品は色落ちや変色の可能性がありますのでご注意ください。
- 本製品の注意事項や対象製品の取扱説明書をよく読みご使用ください。
- 製品の品質向上・改善のため予告なくデザイン・仕様などを変更する場合があります。あらかじめご了承ください。
